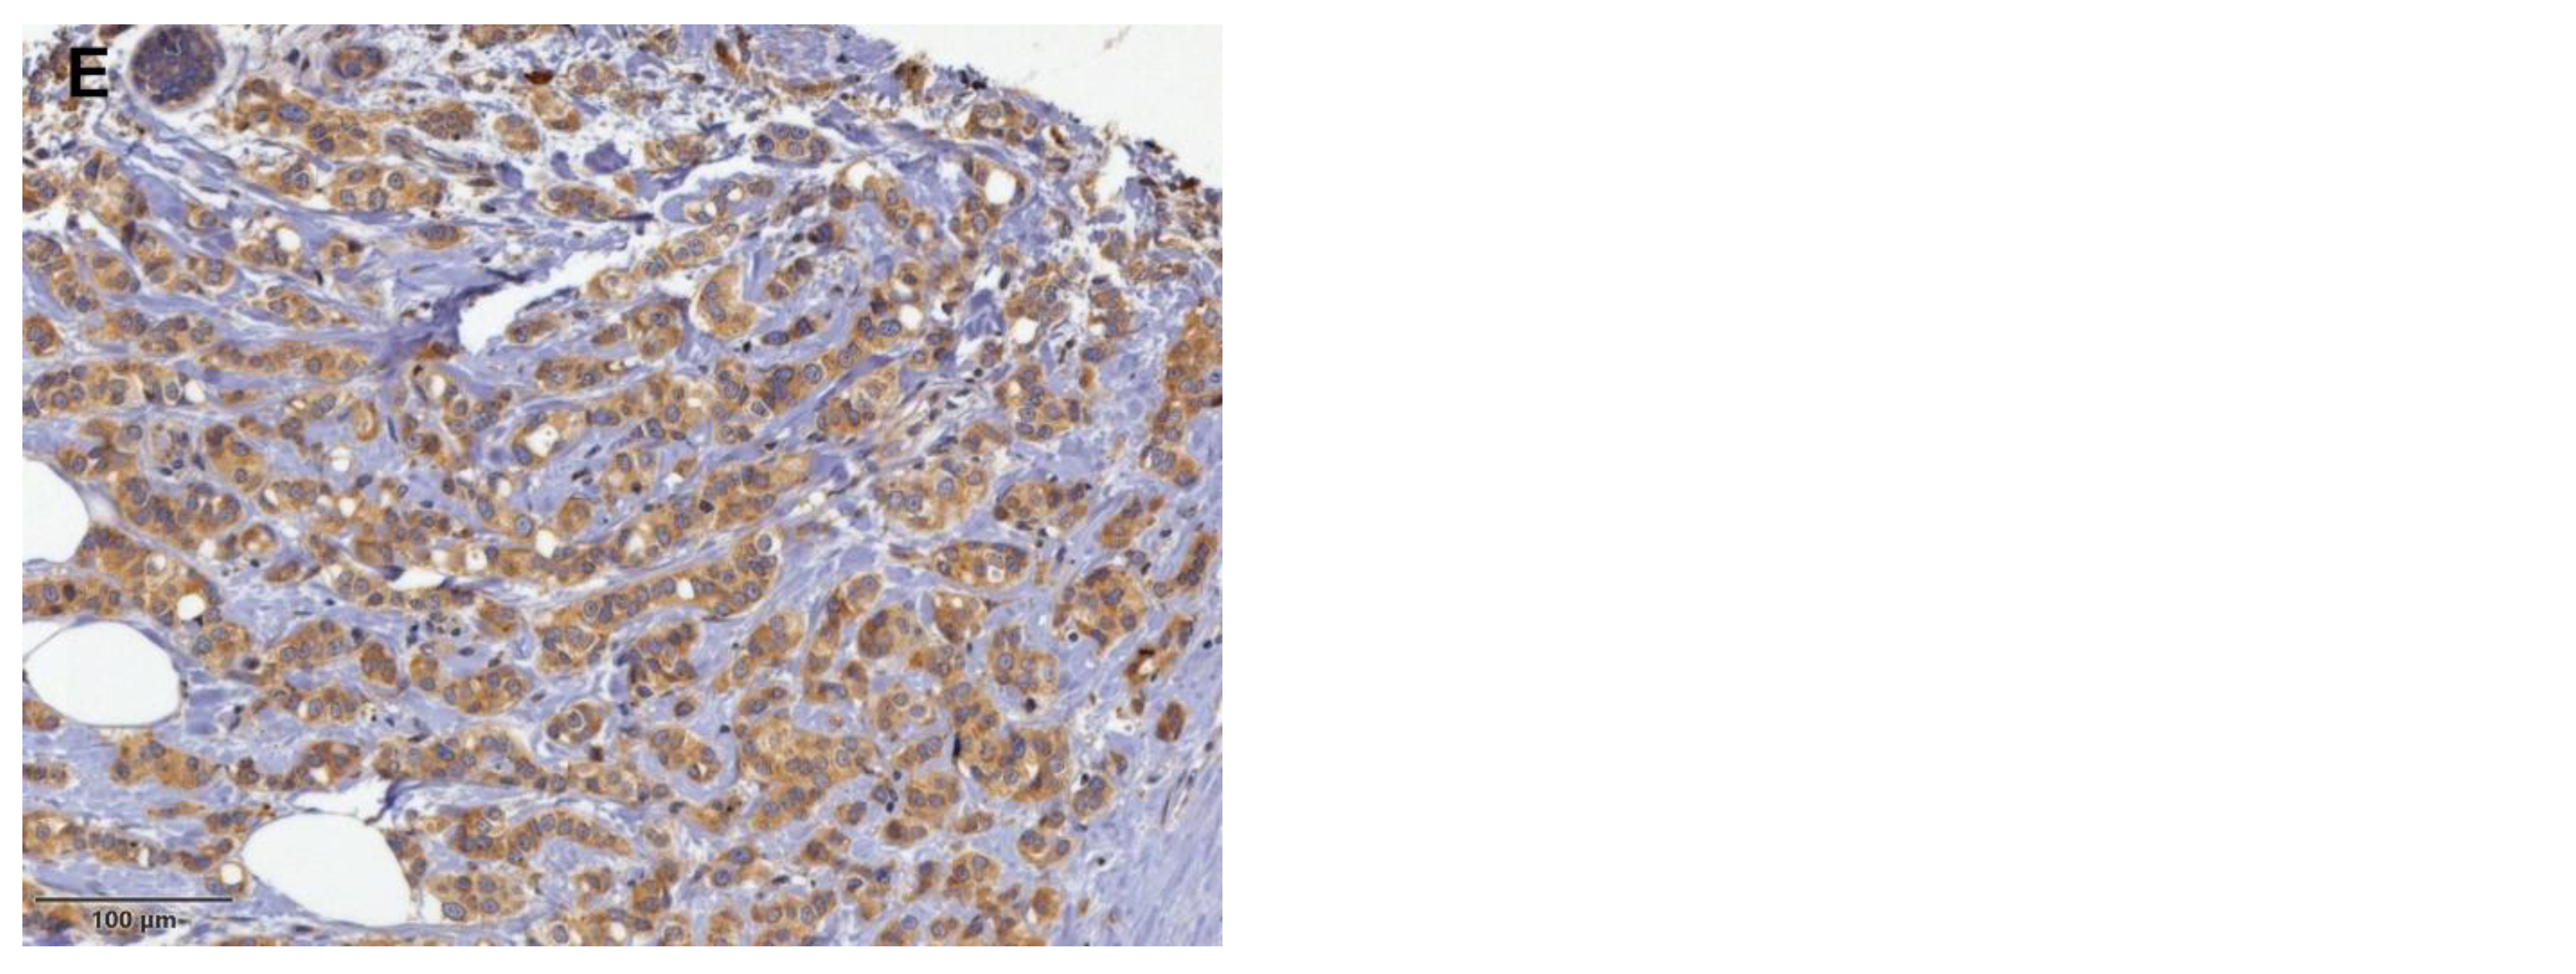
Jcm 13 07665 g001b

Predictive and Prognostic Values of Glycoprotein 96, Androgen Receptors, and Extranodal Extension in Sentinel Lymph Node-Positive Breast Cancer: An Immunohistochemical Retrospective Study
Abstract
1. Introduction
2. Materials and Methods
2.1. Study Cohort
2.2. Immunohistochemical Staining and Analysis
2.3. Real-Time Quantitative Polymerase Chain Reaction (RT-qPCR)
2.4. Statistical Analysis
3. Results
3.1. Clinicopathological Features
3.2. ENE in SLN Is the Strongest Predictor of Non-SLN Status and Also Correlates with the Extent of Nodal Burden
3.3. GP96 Expression Is Associated with HR Status and Recurrence in BC
3.4. Negative AR Expression Correlates with Higher Rates of Locoregional and Distant Recurrence in BC
3.5. Survival Analysis
3.6. GP96 mRNA Is Elevated in BC Tissue Compared to Normal Breast Tissue
4. Discussion
5. Conclusions
Author Contributions
Funding
Institutional Review Board Statement
Informed Consent Statement
Data Availability Statement
Acknowledgments
Conflicts of Interest
References
- Loibl, S.; Poortmans, P.; Morrow, M.; Denkert, C.; Curigliano, G. Epidemiology and risk factors. Breast Cancer Lancet 2021, 397, 1750–1769. [Google Scholar] [CrossRef] [PubMed]
- Guo, L.; Kong, D.; Liu, J.; Zhan, L.; Luo, L.; Zheng, W.; Zheng, Q.; Chen, C.; Sun, S. Breast cancer heterogeneity and its implication in personalized precision therapy. Exp. Hematol. Oncol. 2024, 13, 7, Erratum in Exp. Hematol. Oncol. 2023, 12, 3. [Google Scholar] [CrossRef] [PubMed] [PubMed Central]
- Saleem, M.Z.; Alshwmi, M.; Zhang, H.; Din, S.R.U.; Nisar, M.A.; Khan, M.; Alam, S.; Alam, G.; Jin, L.; Ma, T. Inhibition of JNK-Mediated Autophagy Promotes Proscillaridin A—Induced Apoptosis via ROS Generation, Intracellular Ca+2 Oscillation and Inhibiting STAT3 Signaling in Breast Cancer Cells. Front. Pharmacol. 2020, 11, 01055. [Google Scholar] [CrossRef] [PubMed] [PubMed Central]
- Conti, M.; Morciano, F.; Amodeo, S.; Gori, E.; Romanucci, G.; Belli, P.; Tommasini, O.; Fornasa, F.; Rella, R. Special Types of Breast Cancer: Clinical Behavior and Radiological Appearance. J. Imaging. 2024, 10, 182. [Google Scholar] [CrossRef] [PubMed] [PubMed Central]
- Orrantia-Borunda, E.; Anchondo-Nuñez, P.; Acuña-Aguilar, L.E.; Gómez-Valles, F.O.; Ramírez-Valdespino, C.A. Subtypes of Breast Cancer. In Breast Cancer; Mayrovitz, H.N., Ed.; Exon Publications: Brisbane, Australia, 2022; Chapter 3. [Google Scholar] [PubMed]
- Giuliano, A.E.; Edge, S.B.; Hortobagyi, G.N. Eighth Edition of the AJCC Cancer Staging Manual: Breast Cancer. Ann. Surg. Oncol. 2018, 25, 1783–1785. [Google Scholar] [CrossRef] [PubMed]
- Jahan, N.; Jones, C.; Rahman, R.L. Androgen receptor expression in breast cancer: Implications on prognosis and treatment, a brief review. Mol. Cell Endocrinol. 2021, 531, 111324. [Google Scholar] [CrossRef] [PubMed]
- Hickey, T.E.; Selth, L.A.; Chia, K.M.; Laven-Law, G.; Milioli, H.H.; Roden, D.; Jindal, S.; Hui, M.; Finlay-Schultz, J.; Ebrahimie, E.; et al. The androgen receptor is a tumor suppressor in estrogen receptor-positive breast cancer. Nat. Med. 2021, 27, 310–320. [Google Scholar] [CrossRef] [PubMed]
- You, C.P.; Leung, M.H.; Tsang, W.C.; Khoo, U.S.; Tsoi, H. Androgen Receptor as an Emerging Feasible Biomarker for Breast Cancer. Biomolecules 2022, 12, 72. [Google Scholar] [CrossRef] [PubMed] [PubMed Central]
- Li, L.; Zheng, S.; Chen, M.; Chi, W.; Xue, J.; Wu, J. The Prognostic Values of Androgen Receptor in Breast Cancer. Arch. Pathol. Lab. Med. 2023, 147, 1075–1085. [Google Scholar] [CrossRef] [PubMed]
- Bergen, E.S.; Berghoff, A.S.; Steindl, A.; Rajky, O.; Mercea, P.A.; Kiesel, B.; Tendl-Schulz, K.; Bago-Horvath, Z.; Exner, R.; Fitzal, F.; et al. Androgen Receptor is Expressed in Breast Cancer Brain Metastases. Appl. Immunohistochem. Mol. Morphol. 2021, 29, 728–733. [Google Scholar] [CrossRef] [PubMed]
- Hwang, K.T.; Kim, Y.A.; Kim, J.; Park, J.H.; Choi, I.S.; Hwang, K.R.; Chai, Y.J.; Park, J.H. Influence of Androgen Receptor on the Prognosis of Breast Cancer. J. Clin. Med. 2020, 9, 1083. [Google Scholar] [CrossRef] [PubMed] [PubMed Central]
- Khadela, A.; Chavda, V.P.; Soni, S.; Megha, K.; Pandya, A.J.; Vora, L. Anti-Androgenic Therapies Targeting the Luminal Androgen Receptor of a Typical Triple-Negative Breast Cancer. Cancers 2022, 15, 233. [Google Scholar] [CrossRef] [PubMed] [PubMed Central]
- Li, P.; Yuan, W.; Wu, R.; Zeng, C.; Li, K.; Lu, L. Androgens in Patients with Luminal B and HER2 Breast Cancer Might Be a Biomarker Promoting Anti-PD-1 Efficacy. Front. Oncol. 2022, 12, 917400. [Google Scholar] [CrossRef] [PubMed] [PubMed Central]
- Ahmad, I.; Newell-Fugate, A.E. Role of androgens and androgen receptor in control of mitochondrial function. Am. J. Physiol. Cell Physiol. 2022, 323, C835–C846. [Google Scholar] [CrossRef] [PubMed]
- Hu, C.; Fang, D.; Xu, H.; Wang, Q.; Xia, H. The androgen receptor expression and association with patient’s survival in different cancers. Genomics 2020, 112, 1926–1940. [Google Scholar] [CrossRef] [PubMed]
- Hickey, T.E.; Robinson, J.L.; Carroll, J.S.; Tilley, W.D. Minireview: The androgen receptor in breast tissues: Growth inhibitor, tumor suppressor, oncogene? Mol. Endocrinol. 2012, 26, 1252–1267. [Google Scholar] [CrossRef] [PubMed] [PubMed Central]
- Fan, K.Y.; Chehade, R.; Qazi, M.; Moravan, V.; Nofech-Mozes, S.; Jerzak, K.J. Androgen Receptor Is Expressed in the Majority of Breast Cancer Brain Metastases and Is Subtype-Dependent. Cancers 2023, 15, 2748. [Google Scholar] [CrossRef] [PubMed] [PubMed Central]
- Elias, A.D.; Staley, A.W.; Fornier, M.; Vidal, G.A.; Alami, V.; Sams, S.; Spoelstra, N.S.; Goodspeed, A.; Kabos, P.; Diamond, J.R.; et al. Clinical and immune responses to neoadjuvant fulvestrant with or without enzalutamide in ER+/Her2- breast cancer. NPJ Breast Cancer 2024, 10, 88. [Google Scholar] [CrossRef] [PubMed] [PubMed Central]
- Khan, A.F.; Karami, S.; Peidl, A.S.; Waiters, K.D.; Babajide, M.F.; Bawa-Khalfe, T. Androgen Receptor in Hormone Receptor-Positive Breast Cancer. Int. J. Mol. Sci. 2023, 25, 476. [Google Scholar] [CrossRef] [PubMed] [PubMed Central]
- Anestis, A.; Zoi, I.; Papavassiliou, A.G.; Karamouzis, M.V. Androgen Receptor in Breast Cancer-Clinical and Preclinical Research Insights. Molecules 2020, 25, 358. [Google Scholar] [CrossRef] [PubMed] [PubMed Central]
- Viehweger, F.; Hoop, J.; Tinger, L.M.; Bernreuther, C.; Büscheck, F.; Clauditz, T.S.; Hinsch, A.; Jacobsen, F.; Luebke, A.M.; Steurer, S.; et al. Frequency of Androgen Receptor Positivity in Tumors: A Study Evaluating More Than 18,000 Tumors. Biomedicines 2024, 12, 957. [Google Scholar] [CrossRef] [PubMed] [PubMed Central]
- Sabbatino, E.; Tutino, V.; Licitra, F.; Di Donato, M.; Castoria, G.; Migliaccio, A.; Giovannelli, P. Role of the Androgen Receptor in Gender-Related Cancers. Endocrines 2023, 4, 407–426. [Google Scholar] [CrossRef]
- Michmerhuizen, A.R.; Spratt, D.E.; Pierce, L.J.; Speers, C.W. Are we there yet? Understanding androgen receptor signaling in breast cancer. NPJ Breast Cancer 2020, 6, 47. [Google Scholar] [CrossRef] [PubMed] [PubMed Central]
- Hou, Y.; Peng, Y.; Li, Z. Update on prognostic and predictive biomarkers of breast cancer. Semin. Diagn. Pathol. 2022, 39, 322–332. [Google Scholar] [CrossRef] [PubMed]
- Dowling, G.P.; Keelan, S.; Toomey, S.; Daly, G.R.; Hennessy, B.T.; Hill, A.D.K. Review of the status of neoadjuvant therapy in HER2-positive breast cancer. Front. Oncol. 2023, 13, 1066007. [Google Scholar] [CrossRef] [PubMed] [PubMed Central]
- Li, X.; Wang, B.; Liu, W.; Gui, M.; Peng, Z.; Meng, S. Blockage of conformational changes of heat shock protein gp96 on cell membrane by a α-helix peptide inhibits HER2 dimerization and signaling in breast cancer. PLoS ONE 2015, 10, e0124647. [Google Scholar] [CrossRef] [PubMed] [PubMed Central]
- Duan, X.; Iwanowycz, S.; Ngoi, S.; Hill, M.; Zhao, Q.; Liu, B. Molecular Chaperone GRP94/GP96 in Cancers: Oncogenesis and Therapeutic Target. Front. Oncol. 2021, 11, 629846. [Google Scholar] [CrossRef]
- Buc Calderon, P.; Sennesael, A.L.; Glorieux, C. Glucose-regulated protein of 94 kDa contributes to the development of an aggressive phenotype in breast cancer cells. Biomed. Pharmacother. 2018, 105, 115–120. [Google Scholar] [CrossRef] [PubMed]
- Dejeans, N.; Glorieux, C.; Guenin, S.; Beck, R.; Sid, B.; Rousseau, R.; Bisig, B.; Delvenne, P.; Buc Calderon, P.; Verrax, J. Overexpression of GRP94 in breast cancer cells resistant to oxidative stress promotes high levels of cancer cell proliferation and migration: Implications for tumor recurrence. Free Radic. Biol. Med. 2012, 52, 993–1002. [Google Scholar] [CrossRef] [PubMed]
- Martínez-Aranda, A.; Hernández, V.; Moreno, F.; Baixeras, N.; Cuadras, D.; Urruticoechea, A.; Gil-Gil, M.; Vidal, N.; Andreu, X.; Seguí, M.A.; et al. Predictive and Prognostic Brain Metastases Assessment in Luminal Breast Cancer Patients: FN14 and GRP94 from Diagnosis to Prophylaxis. Front. Oncol. 2017, 7, 283. [Google Scholar] [CrossRef] [PubMed] [PubMed Central]
- Wolff, A.C.; Hammond, M.E.; Hicks, D.G.; Dowsett, M.; McShane, L.M.; Allison, K.H.; Allred, D.C.; Bartlett, J.M.; Bilous, M.; Fitzgibbons, P.; et al. Recommendations for human epidermal growth factor receptor 2 testing in breast cancer: American Society of Clinical Oncology/College of American Pathologists clinical practice guideline update. J. Clin. Oncol. 2013, 31, 3997–4013. [Google Scholar] [CrossRef] [PubMed]
- Wu, B.X.; Hong, F.; Zhang, Y.; Ansa-Addo, E.; Li, Z. GRP94/gp96 in Cancer: Biology, Structure, Immunology, and Drug Development. Adv. Cancer Res. 2016, 129, 165–190. [Google Scholar] [CrossRef] [PubMed]
- Ansa-Addo, E.A.; Thaxton, J.; Hong, F.; Wu, B.X.; Zhang, Y.; Fugle, C.W.; Metelli, A.; Riesenberg, B.; Williams, K.; Gewirth, D.T.; et al. Clients and Oncogenic Roles of Molecular Chaperone gp96/grp94. Curr. Top Med. Chem. 2016, 16, 2765–2778. [Google Scholar] [CrossRef] [PubMed] [PubMed Central]
- Liu, Y.; Zhou, F.; Ali, H.; Lathia, J.D.; Chen, P. Immunotherapy for glioblastoma: Current state, challenges, and future perspectives. Cell Mol. Immunol. 2024, 21, 1354–1375. [Google Scholar] [CrossRef] [PubMed] [PubMed Central]
- Xu, Y.; Li, X.; Cheng, F.; Zhao, B.; Fang, M.; Li, Z.; Meng, S. Heat shock protein gp96 drives natural killer cell maturation and anti-tumor immunity by counteracting Trim28 to stabilize Eomes. Nat. Commun. 2024, 15, 1106. [Google Scholar] [CrossRef] [PubMed] [PubMed Central]
- Padula, L.; Fisher, E.; Strbo, N. “All for One and One for All”: The Secreted Heat Shock Protein gp96-Ig Based Vaccines. Cells 2023, 13, 72. [Google Scholar] [CrossRef] [PubMed] [PubMed Central]
- Albakova, Z. HSP90 multi-functionality in cancer. Front. Immunol. 2024, 15, 1436973. [Google Scholar] [CrossRef] [PubMed] [PubMed Central]
- He, J.; Zhou, Y.; Sun, L. Emerging mechanisms of the unfolded protein response in therapeutic resistance: From chemotherapy to Immunotherapy. Cell Commun. Signal. 2024, 22, 89. [Google Scholar] [CrossRef] [PubMed] [PubMed Central]
- Zhou, L.; Velegraki, M.; Wang, Y.; Mandula, J.K.; Chang, Y.; Liu, W.; Song, N.J.; Kwon, H.; Xiao, T.; Bolyard, C.; et al. Spatial and functional targeting of intratumoral Tregs reverses CD8+ T cell exhaustion and promotes cancer immunotherapy. J. Clin. Invest. 2024, 134, e180080. [Google Scholar] [CrossRef] [PubMed] [PubMed Central]
- Qin, L.; Wang, J.; Cheng, F.; Cheng, J.; Zhang, H.; Zheng, H.; Liu, Y.; Liang, Z.; Wang, B.; Li, C.; et al. GPC3 and PEG10 peptides associated with placental gp96 elicit specific T cell immunity against hepatocellular carcinoma. Cancer Immunol. Immunother. 2023, 72, 4337–4354. [Google Scholar] [CrossRef] [PubMed] [PubMed Central]
- Kim, J.W.; Cho, Y.B.; Lee, S. Cell Surface GRP94 as a Novel Emerging Therapeutic Target for Monoclonal Antibody Cancer Therapy. Cells 2021, 10, 670. [Google Scholar] [CrossRef] [PubMed] [PubMed Central]
- Izadpanah, A.; Delirezh, N.; Mahmodlou, R. Ex vivo Optimization of Glucose-Regulated Protein 94/Glycoprotein 96 Expressions in Mammospheres; Implication for Breast Cancer Immunotherapy. Cell J. 2022, 24, 261–266. [Google Scholar] [CrossRef] [PubMed] [PubMed Central]
- Khorami-Sarvestani, S.; Vanaki, N.; Shojaeian, S.; Zarnani, K.; Stensballe, A.; Jeddi-Tehrani, M.; Zarnani, A.H. Placenta: An old organ with new functions. Front. Immunol. 2024, 15, 1385762. [Google Scholar] [CrossRef] [PubMed] [PubMed Central]
- Lai, B.S.; Tsang, J.Y.; Li, J.J.; Poon, I.K.; Tse, G.M. Anatomical site and size of sentinel lymph node metastasis predicted additional axillary tumour burden and breast cancer survival. Histopathology 2023, 82, 899–911. [Google Scholar] [CrossRef] [PubMed]
- Zhang-Yin, J.; Mauel, E.; Talpe, S. Update on Sentinel Lymph Node Methods and Pathology in Breast Cancer. Diagnostics 2024, 14, 252. [Google Scholar] [CrossRef] [PubMed] [PubMed Central]
- Goldhirsch, A.; Winer, E.P.; Coates, A.S.; Gelber, R.D.; Piccart-Gebhart, M.; Thürlimann, B.; Senn, H.J.; Panel members. Panel members. Personalizing the treatment of women with early breast cancer: Highlights of the St Gallen International Expert Consensus on the Primary Therapy of Early Breast Cancer 2013. Ann Oncol. 2013, 24, 2206–2223. [Google Scholar] [CrossRef] [PubMed] [PubMed Central]
- Ma, X.; Yang, X.; Yang, W.; Shui, R. Prognostic value of extranodal extension in axillary lymph node-positive breast cancer. Sci. Rep. 2021, 11, 9534. [Google Scholar] [CrossRef] [PubMed] [PubMed Central]
- Lester, S.C.; Bose, S.; Chen, Y.Y.; Connolly, J.L.; de Baca, M.E.; Fitzgibbons, P.L.; Hayes, D.F.; Kleer, C.; O’Malley, F.P.; Page, D.L.; et al. Protocol for the Examination of Resection Specimens from Patients with Invasive Carcinoma of the Breast; College of American Pathologists: Northfield, IL, USA, 2020. [Google Scholar]
- Liu, J.; Li, Y.; Zhang, W.; Yang, C.; Yang, C.; Chen, L.; Ding, M.; Zhang, L.; Liu, X.; Cui, G.; et al. The prognostic role of lymph node ratio in breast cancer patients received neoadjuvant chemotherapy: A dose-response meta-analysis. Front. Surg. 2022, 9, 971030. [Google Scholar] [CrossRef] [PubMed] [PubMed Central]
- Cai, Y.; Zhaoxiong, Y.; Zhu, W.; Wang, H. Association between sleep duration, depression and breast cancer in the United States: A national health and nutrition examination survey analysis 2009–2018. Ann. Med. 2024, 56, 2314235. [Google Scholar] [CrossRef] [PubMed] [PubMed Central]
- Rajković-Molek, K.; Mustać, E.; Avirović, M.; Georgev, P.; Demaria, M.; Aničić, J.; Ban, J.; Babarović, E. The expression of calpain-1 and androgen receptor in breast cancer and their correlation with clinicopathological characteristics: An immunohistochemical retrospective study. Pathol. Res. Pract. 2020, 216, 153068. [Google Scholar] [CrossRef] [PubMed]
- de Meric de Bellefon, M.; Lemanski, C.; Ducteil, A.; Fenoglietto, P.; Azria, D.; Bourgier, C. Management of the Axilla in the Era of Breast Cancer Heterogeneity. Front. Oncol. 2018, 8, 84. [Google Scholar] [CrossRef] [PubMed] [PubMed Central]
- Abdulla, H.A.; Salman, A.Z.; Alaraibi, S.J.; Nazzal, K.; Ahmed, S.A.; Almahari, S.A.; Dhaif, A. Risk Factors Associated with Sentinel Lymph Node Metastasis in Clinically Node-Negative Breast Cancer. Eur. J. Breast Health. 2023, 19, 229–234. [Google Scholar] [CrossRef] [PubMed] [PubMed Central]
- Li, Y.; Han, D.; Shen, C. Prediction of the axillary lymph-node metastatic burden of breast cancer by 18F-FDG PET/CT-based radiomics. BMC Cancer. 2024, 24, 704. [Google Scholar] [CrossRef] [PubMed] [PubMed Central]
- Magnoni, F.; Galimberti, V.; Corso, G.; Intra, M.; Sacchini, V.; Veronesi, P. Axillary surgery in breast cancer: An updated historical perspective. Semin. Oncol. 2020, 47, 341–352. [Google Scholar] [CrossRef] [PubMed]
- Harrison, B. Update on sentinel node pathology in breast cancer. Semin. Diagn. Pathol. 2022, 39, 355–366. [Google Scholar] [CrossRef] [PubMed]
- Julian, T.B.; Anderson, S.J.; Krag, D.N.; Harlow, S.P.; Costantino, J.P.; Ashikaga, T.; Weaver, D.L.; Mamounas, E.P.; Wolmark, N. 10-yr follow-up results of NSABP B-32, a randomized phase III clinical trial to compare sentinel node resection (SNR) to conventional axillary dissection (AD) in clinically node-negative breast cancer patients (abstract). J. Clin. Oncol. 2013, 31 (Suppl. S15), 4. [Google Scholar] [CrossRef]
- Galimberti, V.; Cole, B.F.; Zurrida, S.; Viale, G.; Luini, A.; Veronesi, P.; Baratella, P.; Chifu, C.; Sargenti, M.; Intra, M.; et al. IBCSG 23-01 randomised controlled trial comparing axillary dissection versus no axillary dissection in patients with sentinel node micrometastases. Lancet Oncol. 2013, 14, 297–305. [Google Scholar] [CrossRef] [PubMed]
- Galimberti, V.; Cole, B.F.; Viale, G.; Veronesi, P.; Vicini, E.; Intra, M.; Mazzarol, G.; Massarut, S.; Zgajnar, J.; Taffurelli, M.; et al. Axillary dissection versus no axillary dissection in patients with breast cancer and sentinel-node micrometastases (IBCSG 23-01): 10-year follow-up of a randomised, controlled phase 3 trial. Lancet Oncol. 2018, 19, 1385–1393. [Google Scholar] [CrossRef] [PubMed]
- Solá, M.; Alberro, J.A.; Fraile, M.; Santesteban, P.; Ramos, M.; Fabregas, R.; Moral, A.; Ballester, B.; Vidal, S. Complete axillary lymph node dissection versus clinical follow-up in breast cancer patients with sentinel node micrometastasis: Final results from the multicenter clinical trial AATRM 048/13/2000. Ann. Surg Oncol. 2013, 20, 120–127. [Google Scholar] [CrossRef] [PubMed]
- Giuliano, A.E.; Ballman, K.V.; McCall, L.; Beitsch, P.D.; Brennan, M.B.; Kelemen, P.R.; Ollila, D.W.; Hansen, N.M.; Whitworth, P.W.; Blumencranz, P.W.; et al. Effect of Axillary Dissection vs No Axillary Dissection on 10-Year Overall Survival Among Women With Invasive Breast Cancer and Sentinel Node Metastasis: The ACOSOG Z0011 (Alliance) Randomized Clinical Trial. JAMA 2017, 318, 918–926. [Google Scholar] [CrossRef] [PubMed] [PubMed Central]
- Donker, M.; van Tienhoven, G.; Straver, M.E.; Meijnen, P.; van de Velde, C.J.; Mansel, R.E.; Cataliotti, L.; Westenberg, A.H.; Klinkenbijl, J.H.; Orzalesi, L.; et al. Radiotherapy or surgery of the axilla after a positive sentinel node in breast cancer (EORTC 10981-22023 AMAROS): A randomised, multicentre, open-label, phase 3 non-inferiority trial. Lancet Oncol. 2014, 15, 1303–1310. [Google Scholar] [CrossRef] [PubMed] [PubMed Central]
- Sávolt, Á.; Péley, G.; Polgár, C.; Udvarhelyi, N.; Rubovszky, G.; Kovács, E.; Győrffy, B.; Kásler, M.; Mátrai, Z. Eight-year follow up result of the OTOASOR trial: The Optimal Treatment Of the Axilla—Surgery Or Radiotherapy after positive sentinel lymph node biopsy in early-stage breast cancer: A randomized, single centre, phase III, non-inferiority trial. Eur. J. Surg. Oncol. 2017, 43, 672–679. [Google Scholar] [CrossRef] [PubMed]
- Huang, Z.; Wu, Z.; Zou, Q.Q.; Xie, Y.J.; Li, L.H.; Huang, Y.P.; Wu, F.M.; Huang, D.; Pan, Y.H.; Yang, J.R. Risk factors of non-sentinel lymph node metastasis in breast cancer with 1-2 sentinel lymph node macrometastases underwent total mastectomy: A case-control study. World J. Surg. Oncol. 2023, 21, 125. [Google Scholar] [CrossRef] [PubMed] [PubMed Central]
- Choi, A.H.; Blount, S.; Perez, M.N.; Chavez de Paz, C.E.; Rodriguez, S.A.; Surrusco, M.; Garberoglio, C.A.; Lum, S.S.; Senthil, M. Size of Extranodal Extension on Sentinel Lymph Node Dissection in the American College of Surgeons Oncology Group Z0011 Trial Era. JAMA Surg. 2015, 150, 1141–1148. [Google Scholar] [CrossRef] [PubMed]
- Gooch, J.; King, T.A.; Eaton, A.; Dengel, L.; Stempel, M.; Corben, A.D.; Morrow, M. The extent of extracapsular extension may influence the need for axillary lymph node dissection in patients with T1–T2 breast cancer. Ann. Surg. Oncol. 2014, 21, 2897–2903. [Google Scholar] [CrossRef] [PubMed] [PubMed Central]
- Zheng, J.; Cai, S.; Song, H.; Wang, Y.; Han, X.; Wu, H.; Gao, Z.; Qiu, F. Positive non-sentinel axillary lymph nodes in breast cancer with 1-2 sentinel lymph node metastases. Medicine 2018, 97, e13015. [Google Scholar] [CrossRef] [PubMed] [PubMed Central]
- Yang, X.; Ma, X.; Yang, W.; Shui, R. Clinical significance of extranodal extension in sentinel lymph node positive breast cancer. Sci. Rep. 2020, 10, 14684. [Google Scholar] [CrossRef] [PubMed] [PubMed Central]
- O’Keeffe, N.A.; O’Neill, C.; Zahere, A.; Livingstone, V.; Browne, T.J.; Redmond, H.P.; Corrigan, M.A. A quantitative analysis of tumour characteristics in breast cancer patients with extranodal extension in non-sentinel nodes. Breast 2018, 38, 171–174. [Google Scholar] [CrossRef]
- Nottegar, A.; Veronese, N.; Senthil, M.; Roumen, R.M.; Stubbs, B.; Choi, A.H.; Verheuvel, N.C.; Solmi, M.; Pea, A.; Capelli, P.; et al. Extra-nodal extension of sentinel lymph node metastasis is a marker of poor prognosis in breast cancer patients: A systematic review and an exploratory meta-analysis. Eur. J. Surg. Oncol. 2016, 42, 919–925. [Google Scholar] [CrossRef] [PubMed]
- Meretoja, T.J.; Audisio, R.A.; Heikkilä, P.S.; Bori, R.; Sejben, I.; Regitnig, P.; Luschin-Ebengreuth, G.; Zgajnar, J.; Perhavec, A.; Gazic, B.; et al. International multicenter tool to predict the risk of four or more tumor-positive axillary lymph nodes in breast cancer patients with sentinel node macrometastases. Breast Cancer Res. Treat. 2013, 138, 817–827. [Google Scholar] [CrossRef] [PubMed]
- van la Parra, R.F.; Peer, P.G.; Ernst, M.F.; Bosscha, K. Meta-analysis of predictive factors for non-sentinel lymph node metastases in breast cancer patients with a positive SLN. Eur. J. Surg. Oncol. 2011, 37, 290–299. [Google Scholar] [CrossRef] [PubMed]
- Aziz, S.; Wik, E.; Knutsvik, G.; Klingen, T.A.; Chen, Y.; Davidsen, B.; Aas, H.; Aas, T.; Akslen, L.A. Extra-nodal extension is a significant prognostic factor in lymph node positive breast cancer. PLoS ONE 2017, 12, e0171853. [Google Scholar] [CrossRef] [PubMed] [PubMed Central]
- Bucci, J.A.; Kennedy, C.W.; Burn, J.; Gillett, D.J.; Carmalt, H.L.; Donnellan, M.J.; Joseph, M.G.; Pendlebury, S.C. Implications of extranodal spread in node positive breast cancer: A review of survival and local recurrence. Breast 2001, 10, 213–219. [Google Scholar] [CrossRef] [PubMed]
- Tang, P.; Moravek, M.; Oprea-Ilies, G.; Mon, K.S.; Pambuccian, S.E. Extranodal extension, an international survey on its evaluation and reporting in breast cancer patients. Pathol. Res. Pract. 2022, 237, 154070. [Google Scholar] [CrossRef] [PubMed]
- Hodorova, I.; Rybarova, S.; Solar, P.; Vecanova, J.; Prokopcakova, L.; Bohus, P.; Solarova, Z.; Mellova, Y.; Schmidtova, K. Gp96 and its different expression in breast carcinomas. Neoplasma 2008, 55, 31–35. [Google Scholar] [PubMed]
- Ji, F.; Zhang, Y.; Zhu, Z.B.; Guo, Y.; Shen, S.L.; Cao, Q.H.; Li, S.Q.; Peng, B.G.; Liang, L.J.; Hua, Y.P. Low levels of glycoprotein 96 indicate a worse prognosis in early-stage hepatocellular carcinoma patients after hepatectomy. Hum. Pathol. 2019, 86, 193–202. [Google Scholar] [CrossRef] [PubMed]
- Radolovic, P.; Grebic, D.; Mustac, E.; Sebaher, I.; Mamic, J.; Miletic, W.M. Heat shock protein gp96 and CD4+ and CD8+ T-lymphocytes expression as prognostic factors in various molecular types of invasive breast carcinoma. Neoplasma 2020, 67, 421–429. [Google Scholar] [CrossRef] [PubMed]
- Ravaioli, S.; Maltoni, R.; Pasculli, B.; Parrella, P.; Giudetti, A.M.; Vergara, D.; Tumedei, M.M.; Pirini, F.; Bravaccini, S. Androgen receptor in breast cancer: The “5W” questions. Front. Endocrinol. 2022, 13, 977331. [Google Scholar] [CrossRef] [PubMed] [PubMed Central]
- Lee, J.S.; Roh, M.S.; Lee, H.W.; Lee, E.H.; Pak, M.G.; Kim, K.; Nam, H.Y.; Kim, K.M.; Jung, S.B. Prognostic significance of glucose-related protein 94 in colorectal cancer. Pathol. Res. Pract. 2020, 216, 153013. [Google Scholar] [CrossRef] [PubMed]
- You, C.P.; Tsoi, H.; Man, E.P.S.; Leung, M.H.; Khoo, U.S. Modulating the Activity of Androgen Receptor for Treating Breast Cancer. Int. J. Mol. Sci. 2022, 23, 15342. [Google Scholar] [CrossRef] [PubMed] [PubMed Central]
- Brumec , M.; Sobočan , M.; Takač , I.; Arko, D. Clinical Implications of Androgen-Positive Triple-Negative Breast Cancer. Cancers 2021, 13, 1642. [Google Scholar] [CrossRef]

| Characteristics (All) | No. (%) | Non-SLN Status | p Value | ||
|---|---|---|---|---|---|
| Positive | Negative | ||||
| Entire cohort | 107 (100%) | 56 (52.34%) | 51 (47.66%) | 0.630 | |
| Age, years | median (range) | 59 (28–89) | 57 (34–89) | 60 (28–85) | |
| ≤50 years | 29 (27.1%) | 15 (14.02%) | 14 (13.08%) | 0.939 | |
| >50 years | 78 (72.90%) | 41 (38.32%) | 37 (34.58%) | ||
| Breast cancer laterality | left | 51 (47.66%) | 24 (22.43%) | 27 (25.23%) | 0.299 |
| right | 56 (52.34%) | 32 (29.91%) | 24 (22.43%) | ||
| Histologic type | ductal/NST | 85 (79.44%) | 43 (40.19%) | 42 (39.25%) | 0.754 |
| lobular | 14 (13.08%) | 8 (7.48%) | 6 (5.61%) | ||
| others | 8 (7.48%) | 5 (4.67%) | 3 (2.80%) | ||
| Histologic grade | G1 | 41 (38.32%) | 19 (17.76%) | 22 (20.56%) | 0.042 |
| G2 | 50 (46.73%) | 24 (22.43%) | 26 (24.30%) | ||
| G3 | 16 (14.95%) | 13 (12.15%) | 3 (2.80%) | ||
| Tumor size, cm | mean ± std. | 2.57 ± 1.16 | 2.75 ± 1.31 | 2.37 ± 0.94 | 0.087 |
| pT stage | pT1 | 44 (41.12%) | 21 (19.63%) | 23 (21.49%) | 0.427 |
| pT2 | 63 (58.88%) | 35 (32.71%) | 28 (26.17%) | ||
| pN stage | 1 | 68 (63.55%) | 19 (17.76%) | 49 (45.79%) | <0.001 |
| 2 | 39 (36.45%) | 37 (34.58%) | 2 (1.87%) | ||
| Necrosis | absent | 73 (68.22%) | 36 (33.65%) | 37 (34.58%) | 0.361 |
| present | 34 (31.78%) | 20 (18.69%) | 14 (13.08%) | ||
| Calcifications | absent | 62 (57.94%) | 33 (30.84%) | 29 (27.10%) | 0.830 |
| present | 45 (42.06%) | 23 (21.50%) | 22 (20.56%) | ||
| EIC | not evident | 89 (83.18%) | 47 (43.93%) | 42 (39.25%) | 0.829 |
| present | 18 (16.82%) | 9 (8.41%) | 9 (8.41%) | ||
| ER status | negative | 31 (28.97%) | 19 (17.76%) | 12 (11.21%) | 0.239 |
| positive | 76 (71.03%) | 37 (34.58%) | 39 (36.45%) | ||
| PR status | negative | 39 (36.45%) | 22 (20.56%) | 17 (15.88%) | 0.525 |
| positive | 68 (63.55%) | 34 (31.78%) | 34 (31.78%) | ||
| HER2 status | negative | 80 (74.77%) | 40 (37.38%) | 40 (37.38%) | 0.407 |
| positive | 27 (25.23%) | 16 (14.95%) | 11 (10.29%) | ||
| Ki-67 index | <20% | 56 (52.34%) | 28 (26.17%) | 28 (26.17%) | 0.614 |
| ≥20% | 51 (47.66%) | 28 (26.17%) | 23 (21.49%) | ||
| Lymphovascular invasion | negative | 16 (14.95%) | 6 (5.61%) | 10 (9.34%) | 0.200 |
| positive | 91 (85.05%) | 50 (46.73%) | 41 (38.32%) | ||
| Perineural invasion | negative | 30 (28.04%) | 15 (14.02%) | 15 (14.02%) | 0.836 |
| positive | 49 (45.79%) | 25 (23.36%) | 24 (22.43%) | ||
| CBD * | 28 (26.17%) | 16 (14.95%) | 12 (11.22%) | ||
| ENE in SLN | negative | 69 (64.49%) | 28 (26.17%) | 41 (38.32%) | 0.001 |
| positive | 38 (35.51%) | 28 (26.17%) | 10 (9.34%) | ||
| Size of SLN metastasis, mm | mean ± std. | 9.19 ± 6.75 | 11.40 ± 6.68 | 6.80 ± 6.04 | <0.001 |
| AR | <10% | 31 (28.97%) | 17 (15.89%) | 14 (13.08%) | 0.742 |
| ≥10% | 76 (71.03%) | 39 (36.45%) | 37 (34.58%) | ||
| GP96 | low | 84 (78.50%) | 47 (43.93%) | 37 (34.58%) | 0.154 |
| high | 23 (21.50%) | 9 (8.41%) | 14 (13.08%) | ||
| BMI, kg/m2 | ≤25 | 48 (44.86%) | 23 (21.49%) | 25 (23.36%) | 0.459 |
| >25 | 58 (54.21%) | 32 (29.91%) | 26 (24.30%) | ||
| N/A | 1 (0.93%) | ||||
| Type of surgery | mastectomy | 34 (31.78%) | 24 (22.43%) | 10 (9.34%) | 0.010 |
| BCS | 73 (68.22%) | 32 (29.91%) | 41 (38.32%) | ||
| Molecular subtype | luminal A | 34 (31.77%) | 18 (16.82%) | 16 (14.95%) | 0.750 |
| luminal B/HER2- | 36 (33.64%) | 16 (14.95%) | 20 (18.69%) | ||
| luminal B/HER2+ | 6 (5.61%) | 3 (2.80%) | 3 (2.80%) | ||
| HER2-enriched | 21 (19.63%) | 13 (12.15%) | 8 (7.48%) | ||
| triple-negative | 10 (9.35%) | 6 (5.61%) | 4 (3.74%) | ||
| Characteristics (All) | Univariable Analysis | Multivariable Analysis | ||
|---|---|---|---|---|
| OR (95% CI) | p Value | OR (95% CI) | p Value | |
| Age (continuous) | 0.999 (0.972–1.029) | 0.978 | ||
| Histologic type, special vs. ductal | 1.411 (0.545–3.649) | 0.478 | ||
| Histologic grade, G3 vs. G1, G2 | 4.837 (1.291–18.128) | 0.019 | 3.050 (0.706–13.168) | 0.0135 |
| pT stage, pT2 vs. pT1 | 1.369 (0.632–2.965) | 0.426 | ||
| Necrosis, present vs. absent | 1.468 (0.645–3.343) | 0.360 | ||
| Calcifications, present vs. absent | 0.919 (0.426–1.981) | 0.829 | ||
| EIC, positive vs. negative | 0.894 (0.324–2.462) | 0.828 | ||
| HR status, positive vs. negative | 0.599 (0.256–1.404) | 0.238 | ||
| HER2 status, positive vs. negative | 1.455 (0.601–3.521) | 0.406 | ||
| Ki-67 index, ≥20% vs. <20% | 1.217 (0.569–2.605) | 0.612 | ||
| LVI, positive vs. negative | 2.033 (0.681–6.064) | 0.204 | ||
| Perineural invasion, positive vs. negative | 1.042 (0.420–2.585) | 0.930 | ||
| ENE in SLN, positive vs. negative | 4.100 (1.722–9.760) | 0.001 | 2.696 (1.051–6.914) | 0.039 |
| Size of SLN metastasis, mm | 1.135 (1.052–1.225) | 0.001 | 1.103 (1.021–1.193) | 0.013 |
| No. of positive SLN | 1.734 (1.029–2.921) | 0.039 | 1.496 (0.865–2.588) | 0.150 |
| AR, ≥10% vs. <10% | 0.868 (0.375–2.007) | 0.741 | ||
| GP96, high vs. low | 0.506 (0.197–1.298) | 0.156 | ||
| BMI (kg/m2), >25 vs. ≤25 | 1.338 (0.621–2.881) | 0.457 | ||
| Characteristics (All) | AR | p Value | GP96 | p Value | ||
|---|---|---|---|---|---|---|
| <10% | ≥10% | Low | High | |||
| No. (%) | No. (%) | No. (%) | No. (%) | |||
| Age, years | ||||||
| ≤50 years | 9 (8.41%) | 20 (18.69%) | 0.775 | 22 (20.56%) | 7 (6.54%) | 0.686 |
| >50 years | 22 (20.56%) | 56 (52.34%) | 62 (57.95%) | 16 (14.95%) | ||
| BC laterality | ||||||
| left | 12 (11.21%) | 39 (36.45%) | 0.239 | 39 (36.45%) | 12 (11.21%) | 0.627 |
| right | 19 (17.76%) | 37 (34.58%) | 45 (42.06%) | 11 (10.28%) | ||
| Histologic type | ||||||
| ductal/NST | 23 (21.50%) | 62 (57.95%) | 0.086 | 65 (60.75%) | 20 (18.69%) | 0.372 |
| lobular | 3 (2.80%) | 11 (10.28%) | 13 (12.15%) | 1 (0.93%) | ||
| others | 5 (4.67%) | 3 (2.80%) | 6 (5.61%) | 2 (1.87%) | ||
| Histologic grade | ||||||
| 1 | 12 (11.21%) | 29 (27.10%) | 0.676 | 34 (31.77%) | 7 (6.54%) | 0.227 |
| 2 | 13 (12.15%) | 37 (34.58%) | 40 (37.38%) | 10 (9.35%) | ||
| 3 | 6 (5.61%) | 10 (9.35%) | 10 (9.35%) | 6 (5.61%) | ||
| pT stage | ||||||
| pT1 | 11 (10.28%) | 33 (30.84%) | 0.451 | 34 (31.77%) | 10 (9.35%) | 0.796 |
| pT2 | 20 (18.69%) | 43 (40.19%) | 50 (46.73%) | 13 (12.15%) | ||
| pN stage | ||||||
| 1 | 22 (20.56%) | 46 (42.99%) | 0.311 | 52 (48.60%) | 16 (14.95%) | 0.501 |
| 2 | 9 (8.41%) | 30 (28.04%) | 32 (29.91%) | 7 (6.54%) | ||
| Necrosis | ||||||
| absent | 19 (17.76%) | 54 (50.47%) | 0.328 | 59 (55.14%) | 14 (13.08%) | 0.395 |
| present | 12 (11.21%) | 22 (20.56%) | 25 (23.37%) | 9 (8.41%) | ||
| Calcifications | ||||||
| absent | 22 (20.56%) | 40 (37.38%) | 0.083 | 45 (42.05%) | 17 (15.89%) | 0.081 |
| present | 9 (8.41%) | 36 (33.65%) | 39 (36.45%) | 6 (5.61%) | ||
| EIC | ||||||
| not evident | 27 (25.24%) | 62 (57.94%) | 0.491 | 72 (67.29%) | 17 (15.89%) | 0.182 |
| present | 4 (3.74%) | 14 (13.08%) | 12 (11.21%) | 6 (5.61%) | ||
| ER status | ||||||
| negative | 17 (15.89%) | 14 (13.08%) | <0.001 | 15 (14.02%) | 16 (14.95%) | <0.001 |
| positive | 14 (13.08%) | 62 (57.95%) | 69 (64.49%) | 7 (6.54%) | ||
| PR status | ||||||
| negative | 19 (17.76%) | 20 (18.69%) | <0.001 | 22 (20.56%) | 17 (15.89%) | <0.001 |
| positive | 12 (11.21%) | 56 (52.34%) | 62 (57.94%) | 6 (5.61%) | ||
| HER2 status | ||||||
| negative | 21 (19.62%) | 59 (55.14%) | 0.288 | 68 (63.55%) | 12 (11.21%) | 0.005 |
| positive | 10 (9.35%) | 17 (15.89%) | 16 (14.96%) | 11 (10.28%) | ||
| Ki-67 index | ||||||
| <20% | 15 (14.02%) | 41 (38.32%) | 0.603 | 49 (45.80%) | 7 (6.54%) | 0.018 |
| ≥20% | 16 (14.95%) | 35 (32.71%) | 35 (32.71%) | 16 (14.95%) | ||
| LVI | ||||||
| negative | 4 (3.74%) | 12 (11.22%) | 0.705 | 13 (12.15%) | 3 (2.80%) | 0.773 |
| positive | 27 (25.23%) | 64 (59.81%) | 71 (66.36%) | 20 (18.69%) | ||
| Perineural invasion | ||||||
| negative | 11 (10.28%) | 19 (17.76%) | 0.083 | 22 (20.56%) | 8 (7.48%) | 0.483 |
| positive | 9 (8.41%) | 40 (37.38%) | 41 (38.32%) | 8 (7.48%) | ||
| CBD * | 11 (10.28%) | 17 (15.89%) | 21 (19.62%) | 7 (6.54%) | ||
| ENE in SLN | ||||||
| negative | 21 (19.63%) | 48 (44.86%) | 0.655 | 51 (47.67%) | 18 (16.82%) | 0.121 |
| positive | 10 (9.34%) | 28 (26.17%) | 33 (30.84%) | 5 (4.67%) | ||
| Non-SLN status | ||||||
| negative | 14 (13.08%) | 37 (34.58%) | 0.742 | 37 (34.58%) | 14 (13.08%) | 0.154 |
| positive | 17 (15.89%) | 39 (36.45%) | 47 (43.93%) | 9 (8.41%) | ||
| BMI, kg/m2 | ||||||
| ≤25 | 14 (13.08%) | 34 (31.78%) | 0.858 | 35 (32.71%) | 13 (12.15%) | 0.223 |
| >25 | 16 (14.96%) | 42 (39.25%) | 48 (44.86%) | 10 (9.35%) | ||
| N/A | 1 (0.93%) | - | 1 (0.93%) | - | ||
| Molecular subtype | ||||||
| Luminal A | 6 (5.61%) | 28 (26.18%) | <0.001 | 32 (29.91%) | 2 (1.87%) | <0.001 |
| Luminal B/HER2− | 7 (6.54%) | 29 (27.10%) | 32 (29.91%) | 4 (3.74%) | ||
| Luminal B/HER2+ | 1 (0.93%) | 5 (4.67%) | 5 (4.67%) | 1 (0.93%) | ||
| HER2-enriched | 9 (8.41%) | 12 (11.21%) | 11 (10.28%) | 10 (9.34%) | ||
| Triple-negative | 8 (7.48%) | 2 (1.87%) | 4 (3.74%) | 6 (5.61%) | ||
| Characteristics (All) | Overall Survival | |||
|---|---|---|---|---|
| Univariable Analysis | Multivariable Analysis | |||
| HR (95% CI) | p Value | HR (95% CI) | p Value | |
| Age (continuous) | 1.035 (1.004–1.066) | 0.028 | 1.052 (1.020–1.085) | 0.001 |
| Histologic type, special vs. ductal | 1.927 (0.871–4.263) | 0.105 | ||
| Histologic grade, G3 vs. G1, G2 | 3.287 (1.483–7.286) | 0.003 | 3.235 (1.257–8.330) | 0.015 |
| pT stage, pT2 vs. pT1 | 1.852 (0.815–4.205) | 0.141 | ||
| Necrosis, present vs. absent | 1.698 (0.803–3.590) | 0.166 | ||
| Calcifications, present vs. absent | 0.433 (0.184–1.019) | 0.055 | ||
| EIC, positive vs. negative | 2.383 (1.046–5.429) | 0.039 | 2.806 (1.165–6.758) | 0.021 |
| HR status, positive vs. negative | 0.522 (0.246–1.104) | 0.089 | ||
| HER2 status, positive vs. negative | 1.146 (0.504–2.608) | 0.745 | ||
| Ki-67 index, ≥20% vs. <20% | 1.849 (0.865–3.951) | 0.113 | ||
| LVI, positive vs. negative | 0.804 (0.305–2.120) | 0.659 | ||
| Perineural invasion, positive vs. negative | 0.528 (0.233–1.196) | 0.126 | ||
| ENE, positive vs. negative | 2.087 (0.987–4.414) | 0.054 | ||
| Non-SLN status, positive vs. negative | 3.339 (1.418–7.860) | 0.005 | 1.689 (0.517–5.520) | 0.386 |
| AR, ≥10% vs. <10% | 0.537 (0.254–1.136) | 0.104 | ||
| GP96, high vs. low | 1.247 (0.530–2.934) | 0.614 | ||
| LNR (continuous) | 1.032 (1.011–1.053) | 0.002 | 1.031 (1.001–1.063) | 0.044 |
| BMI (kg/m2), >25 vs. ≤25 | 0.762 (0.358–1.621) | 0.480 | ||
| Characteristics (All) | Disease-Recurrence-Free Survival | |||
|---|---|---|---|---|
| Univariable Analysis | Multivariable Analysis | |||
| HR (95% CI) | p Value | HR (95% CI) | p Value | |
| Age (continuous) | 1.002 (0.969–1.035) | 0.928 | ||
| Histologic type, special vs. ductal | 1.890 (0.769–4.645) | 0.165 | ||
| Histologic grade, G3 vs. G1, G2 | 2.899 (1.130–7.435) | 0.027 | 3.280 (1.218–8.837) | 0.019 |
| pT stage, pT2 vs. pT1 | 1.576 (0.642–3.867) | 0.321 | ||
| Necrosis, present vs. absent | 1.067 (0.435–2.620) | 0.887 | ||
| Calcifications, present vs. absent | 0.745 (0.312–1.776) | 0.506 | ||
| EIC, positive vs. negative | 2.743 (1.112–6.765) | 0.028 | 2.920 (1.138–7.493) | 0.026 |
| HR status, positive vs. negative | 0.384 (0.166–0.888) | 0.025 | 0.776 (0.285–2.114) | 0.620 |
| HER2 status, positive vs. negative | 1.673 (0.700–4.001) | 0.247 | ||
| Ki-67 index, ≥20% vs. <20% | 2.720 (1.108–6.681) | 0.029 | 1.786 (0.659–4.842) | 0.254 |
| LVI, positive vs. negative | 1.183 (0.349–4.009) | 0.787 | ||
| Perineural invasion, positive vs. negative | 0.806 (0.324–2.005) | 0.642 | ||
| ENE, positive vs. negative | 2.478 (1.058–5.806) | 0.037 | 2.585 (0.876–7.627) | 0.085 |
| Non-SLN status, positive vs. negative | 2.479 (1.009–6.091) | 0.048 | 0.748 (0.213–2.621) | 0.650 |
| AR, ≥10% vs. <10% | 0.397 (0.172–0.916) | 0.030 | 0.304 (0.129–0.714) | 0.006 |
| GP96, high vs. low | 1.454 (0.569–3.718) | 0.435 | ||
| LNR (continuous) | 1.033 (1.010–1.056) | 0.005 | 1.043 (1.016–1.070) | 0.001 |
| BMI (kg/m2), >25 vs. ≤25 | 0.830 (0.360–1.914) | 0.662 | ||
Disclaimer/Publisher’s Note: The statements, opinions and data contained in all publications are solely those of the individual author(s) and contributor(s) and not of MDPI and/or the editor(s). MDPI and/or the editor(s) disclaim responsibility for any injury to people or property resulting from any ideas, methods, instructions or products referred to in the content. |
© 2024 by the authors. Licensee MDPI, Basel, Switzerland. This article is an open access article distributed under the terms and conditions of the Creative Commons Attribution (CC BY) license (https://creativecommons.org/licenses/by/4.0/).
Share and Cite
Klarica Gembić, T.; Grebić, D.; Gulić, T.; Golemac, M.; Avirović, M. Predictive and Prognostic Values of Glycoprotein 96, Androgen Receptors, and Extranodal Extension in Sentinel Lymph Node-Positive Breast Cancer: An Immunohistochemical Retrospective Study. J. Clin. Med. 2024, 13, 7665. https://doi.org/10.3390/jcm13247665
Klarica Gembić T, Grebić D, Gulić T, Golemac M, Avirović M. Predictive and Prognostic Values of Glycoprotein 96, Androgen Receptors, and Extranodal Extension in Sentinel Lymph Node-Positive Breast Cancer: An Immunohistochemical Retrospective Study. Journal of Clinical Medicine. 2024; 13(24):7665. https://doi.org/10.3390/jcm13247665
Chicago/Turabian StyleKlarica Gembić, Tihana, Damir Grebić, Tamara Gulić, Mijo Golemac, and Manuela Avirović. 2024. "Predictive and Prognostic Values of Glycoprotein 96, Androgen Receptors, and Extranodal Extension in Sentinel Lymph Node-Positive Breast Cancer: An Immunohistochemical Retrospective Study" Journal of Clinical Medicine 13, no. 24: 7665. https://doi.org/10.3390/jcm13247665
APA StyleKlarica Gembić, T., Grebić, D., Gulić, T., Golemac, M., & Avirović, M. (2024). Predictive and Prognostic Values of Glycoprotein 96, Androgen Receptors, and Extranodal Extension in Sentinel Lymph Node-Positive Breast Cancer: An Immunohistochemical Retrospective Study. Journal of Clinical Medicine, 13(24), 7665. https://doi.org/10.3390/jcm13247665

